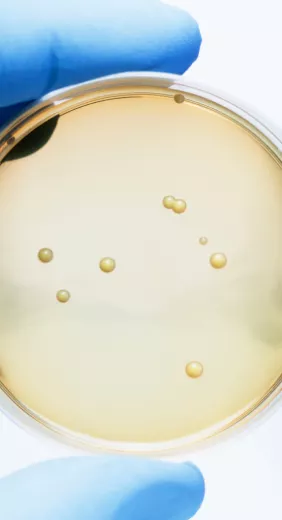

О нас
Пионер в исследованиях микробиоты, компания «Биокодекс» основала в 2017 году Микробиота Институт Биокодекс, нерекламный центр знаний о микробиоте. На веб-сайте Института строго запрещено упоминание названий лекарственных препаратов, фармацевтической продукции и коммерческих названий штаммов. Опыт, научная достоверность, польза и вовлеченность — главные составляющие нашей повседневной деятельности.
- Узнайте все о микробиоте
- Микробиота и связанные с ней расстройства
- Позаботьтесь о своей микрофлоре
-
Публикации
- Об институте
Раздел специалистов здравоохранения
Найдите здесь свое выделенное место
en_sources_title
en_sources_text_start en_sources_text_end
Делиться - значит заботиться
Возможно, эта тема заинтересует ваших друзей. Почему бы не поделиться ею?
Разделы
Об этой статье

ЭКСПЕРТНАЯ ОБЛАСТЬ
Мы являемся экспертами в области изучения микробиоты
Микробиота Институт Биокодекс — это увлеченная, опытная и мотивированная команда экспертов по научной коммуникации, журналистов, специалистов по цифровому маркетингу и практикантов, занимающихся предоставлением и распространением информации о микробиоте и ее значимости. Для выполнения этой миссии нас поддерживают выдающиеся эксперты по микробиоте из 27 стран.
200+ профессионалов
Более 230 исследователей и медицинских работников различных специальностей сотрудничают с Микробиота Институт Биокодекс с момента его создания в 2017 году. Вместе мы объединяем усилия и навыки для продвижения исследований микробиоты (кишечной, вагинальной, а также - кожи, легких...) и повышения осведомленности о ее важных функциях.
Целеустремленная команда
Мы работаем над поддержанием здоровья вашей микробиоты

ДОСТОВЕРНОСТЬ
Мы верим в науку
Редакционный комитет
Научная достоверность — девиз Микробиота Институт Биокодекс. Один раз в месяц редакционный комитет Института отбирает ряд научных публикаций для включения в еженедельные выпуски новостей.
При выборе Комитет руководствуется научным качеством статей, ясностью изложения и актуальностью для области микробиоты, охватываемой Институтом. Редакционный комитет принимает окончательное решение относительно публикации и каждую неделю отбирает статьи в периодических изданиях с высоким фактором влияния. Мы предоставляем медицинским работникам и широкой аудитории точный и на 100% научный контент.
Написано людьми для людей
Все материалы, доступные на веб-сайте Института (статьи, инфографика, курс непрерывного медицинского образования (CME), журнал «Вестник Микробиоты», видеоролики с участием экспертов, изображения...), написаны людьми.
В наших материала полностью отсутствует контент, сгенерированный программами на основе искусственного интеллекта, машинного обучения или похожих алгоритмических инструментов. Мы работаем с независимыми научными журналистами и редакторами, специализирующимися в области микробиоты. В соответствии с редакционными требованиями Института, наши научные журналисты пользуются надежными и ценными ресурсами для поддержания самых высоких стандартов редакционной практики.
Журнал для специалистов здравоохранения
Венец нашей работы — Журнал для специалистов здравоохранения — экспертный журнал для знатоков микробиоты.
Журнал для специалистов здравоохранения выходит три раза в год и доступен на 5 языках (французский, английский, испанский, португальский и русский). На страницах журнала международные эксперты обсуждают достижения в области исследований микробиоты и ее влияния на здоровье человека. С 2023 года «Журнал для специалистов здравоохранения» дает исследователям возможность опубликовать резюме своей оригинальной статьи с инновационными и научно достоверными данными, показывающими четкую связь между кишечной микробиотой, здоровьем и болезнями.
Больше о Журнал для специалистов здравоохранения:

ПОЛЬЗА
Мы предоставляем медицинским работникам и общественности полезные, надежные, современные инструменты и контент
Основная миссия Микробиота Институт Биокодекс — просветительская: как можно более широкое распространение знаний о важности микробиоты.
Институт — поставщик контента для широкой аудитории:
Будем на связи:
Институт является поставщиком контента для медицинских работников:
Институт является поставщиком инструментов для медицинских работников:
Оставайтесь на связи:
Институт является поставщиком данных:
Международный проект «Microbiota Observatory»: Микробиота Институт Биокодекс предложил компании Ipsos провести крупный международный опрос 6500 человек в 7 странах (Франция, Испания, Португалия, США, Бразилия, Мексика и Китай), чтобы определить уровень знаний населения о микробиоте. Ознакомьтесь с результатами.
Международный обзор по микробиоте

ВОВЛЕЧЕННОСТЬ
Мы полностью поддерживаем глобальные инициативы в области здравоохранения, связанные с микробиотой, и активно поддерживаем международные ассоциации.
СРК, эндометриоз, избыточный вес, болезнь Альцгеймера, болезнь Паркинсона, тревожные расстройства, онкологические заболевания, и также - антибиотикорезистентность… Многие заболевания и проблемы, связанные с микробиотой, выходят за рамки отдельных государств и требуют сотрудничества между учеными, ассоциациями пациентов и медицинскими обществами по всему миру. По этой причине Институт поддерживается всемирными медицинскими обществами и ассоциациями пациентов, такими как:
Далее приведены некоторые примеры нашего взаимодействия:
- Проводится с 18 по 24 ноября начиная с 2015 года. Всемирная неделя осведомленности о резистентности к противомикробным препаратам направлена на повышение осведомленности об этом глобальном явлении и призывает широкую общественность, медицинских работников и лиц, принимающих решения, к осторожному использованию антибиотиков, чтобы остановить дальнейший рост антибиотикорезистентности.
- Каждый год Микробиота Институт Биокодекс активно участвует в этой инициативе, производя и делясь эксклюзивными материалами о влиянии противомикробных препаратов на кишечную микробиоту.
• По случаю Месяца осведомленности о СРК Микробиота Институт Биокодекс запустил платформу «Истории пациентов», где размещает видеоролики, в которых пациенты рассказывают о своих хронических заболеваниях. Первые эпизоды были выпущены при поддержке Французской ассоциации пациентов с синдромом раздраженного кишечника (APSSII).
• Большинство пациентов с СРК проходят долгий и тяжелый путь, который включает трудности с постановкой правильного диагноза, отсутствие достоверной информации, неэффективное лечение, неправильные или даже вредные изменения в рационе питания. Вот почему три всемирно известных гастроэнтеролога при поддержке Микробиота Институт Биокодекс разработали руководство по улучшению диагностики СРК. Этот практический и инновационный инструмент предоставляет простой в использовании перечень критериев для дифференциальной диагностики (диагностические критерии, подтипы СРК, перечень настораживающих признаков и симптомов и т. д.) и улучшения коммуникации с пациентами.
- Каждый год Микробиота Институт Биокодекс и Фонд исследований в области эндометриоза проводят во Франции кампанию с целью повышения осведомленности широкой общественности и работников здравоохранения о возможных связях между микробиотой и эндометриозом.
- В преддверии Месяца информирования об эндометриозе Микробиота Институт предоставляет слово трем экспертам в этой области. Какие бывают симптомы? Как диагностируют заболевание? В чем заключается лечение? Имеется ли связь с микробиотой? В этой статье вы найдете ответы на интересующие вас вопросы
BMI 21.06
Настоящая страница содержит контактные данные и не заменяет собой консультацию врача. Компания БИОКОДЕКС не отвечает на вопросы, касающиеся общей медицинской информации или состояния здоровья конкретного пациента. При возникновении вопросов о конкретном заболевании просим обращаться к соответствующим специалистам.
Если вы хотите сообщить о нежелательном(ых) явлении(ях) или пожаловаться на качество продукции БИОКОДЕКС, или у вас имеются вопросы, связанные с продукцией Компании, перейдите по этой ссылке.